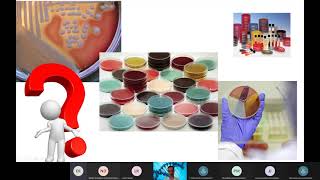

Video Aula 7 - Microbiologia / Identificação de bactérias
4.22k views1286 WordsCopy TextShare

bebelazevedo10
Universidade Estadual do Maranhão
Curso de Medicina Veterinária
Disciplina Microbiologia
Prática Ilu...
Video Transcript:
E aí oi oi pessoal já aviãozinho outras aulas como cultivar micro-organismos em laboratório mas imagine que a gente fez ou uma amostra clínica de um animal ou uma nossa de alimento e cresceu uma bactéria na placa Isso significa que essa bactéria que foi cultivada tá deixando o animal doente ou o alimento impróprio para consumo não necessariamente para eu tirar essa conclusão eu preciso saber quem bactéria é essa que foi isolada então aula de hoje nós vamos ver algumas técnicas utilizadas para identificar bactérias cultivadas in vitro a identificação dos microrganismos Além disso é importante que o
diagnóstico Clínico também é usada no controle de processos de fabricação e manipulação para garantia da segurança de alimentos Além disso ainda é essencial para tomada de decisão de ações corretivas em caso de contaminações ou na avaliação da higienização de ambientes controlados e apresento aulas de tratamento intensivo em hospitais nós já Vimos que eu venho utilizado para isolamento de microrganismos em laboratório pode ser não seletivo por exemplo nesse meio crescem a maioria das bactérias não fastidiosas aquelas que não são muito exigentes nutricionalmente falamos um exemplo é o htpc a Ágata padrão de Contagem o meio também
pode ser seletivo quando eles ter esse ONU os microrganismos com base em uma determinada característica um exemplo é o h sabor ou favorece o crescimento de fungos em detrimento de bactérias e também Existem os meios diferenciais que fazem com que micro-organismos diferentes apresentam algumas características culturais de diferentes um exemplo é o agarrar com quem que diferencia bactérias que fermentam naquelas que não fermentam à lactose e além do meio de outubro utilizado a gente também precisa pensar na temperatura e na atmosfera de Formação uma vez que elas são fundamentais para que você tenha sucesso ao isolamento
de microrganismos o microrganismo que cresce a temperatura ótima de 35 graus por exemplo pode não crescer se foi encontrado a 20 graus ou um microorganismo anaeróbio estrito não precisará se não for cultivado em condições de anaerobiose aqui o tem uma jarra de anaerobiose se eu quero que eu tive um microorganismo anaeróbio eu ir no cálculo na placa outubro normalmente mas antes de colocar na estufa eu coloco dentro da jarra e Oi e para criar um ambiente anaeróbio eu coloco uma vela Oi fixo Acenda a vela a inveja bem a tampa e E aí o condutor
o oxigênio dentro da jarra for consumido pelo for ele vai se apagar então se eu quero continuar no grupo de mesmos anaeróbios É só colocar na jarra e colocar jarra com as placas ou todos inoculadas dentro da estufa se a intenção for cultivar micro-organismos aeróbios aí a gente coloca as placas ou tubos normalmente como já fizemos outras vezes o oxigênio para finalizando sempre utilizando a temperatura adequada crescimento do microrganismo que eu quero continuar oxigênio lá dentro já foi todo consumido e a gente criou um ambiente anaeróbio para o crescimento de micro-organismos né e a identificação
de um micro-organismo começa pela análise da morfologia das colônias que esses micro-organismos forma numa placa com meio de cultura eu faço análise visual das colônias crescidas por exemplo ou segunda que essa placa as colônias crescidas são grandes ou pequenas são pigmentadas ou não se elas são pigmentadas são que cor é uma coluna Lisa ou rugosa é brilhante ou é opaca possui alguma a sua volta cada um microorganismo apresenta uma característica específica quando cresce em um determinado meio e observando a morfologia das colônias já é possível sugerir Qual o microorganismo em questão após análise das características
culturais A análise por técnicas de coloração também é bastante útil na identificação do micro-organismo com a coloração de gram por exemplo que nós já vimos podemos identificar a questão é gran positiva ou negativa a coloração de ziehl-neelsen permite identificar bastonetes álcool-ácido resistentes além dessas muito utilizar as também existem outras técnicas especiais de coloração que permitem por exemplo identificar estruturas com esporos ou projetos e também podem auxiliar na identificação dos microrganismos Então até agora nós vimos que as características culturais e análise da morfologia por técnicas de coloração podem ajudar no início da identificação de bactérias mas
nesses métodos sozinhos não permitem que a gente veja características da fisiologia das células para isso a gente utiliza testes bioquímicos com eles a gente consegue identificar ou classificar as bactérias de acordo com as suas propriedades metabólicas que são únicas para cada espécie os resultados dos Testes bioquímicos são sempre espécies como por o ou negativo E aí a gente utiliza chaves para a identificação de acordo com essas características pré-estabelecidas nessa tabela aqui por exemplo a gente consegue ver os resultados dos testes bioquímicos para as bactérias da família enterobacteriaceae vamos ver então alguns exemplos de testes bioquímicos
utilizados para identificação de bactérias o teste da catalase é um teste bem simples e rápido que permite identificar microorganismos produtores da enzima catalase eu tenho aqui duas placas são microrganismos cultivados Então vou colocar duas gotas de peróxido de hidrogênio numa lâmina de vidro eu vou colocar uma alçada de cada microrganismo em cada conta eu coloquei o primeiro microrganismo não aconteceu nada e não Facebook E aí E aí eu consigo ver formação de bolhas que significa que esse microrganismo produz a enzima catalase e a catalase ela quebra molécula de peróxido de hidrogênio e água e oxigênio
e a gente observa essa reação por meio da formação de bolhas nós vamos fazer agora o teste do vermelho de metila tenho aqui dois cultivos bacterianos recentes algumas bactérias fermentam a glicose presente no meio produzindo grandes quantidades de ácidos esses frascos baixa o PH do meio de cultivo para menos de 5 ou vermelho de metila é um indicador de PH quando ele é adicionado a um meio como PH menor do que 5 e meio esse meio vai apresentar a cor amarela quando ele colocava no meio com ph maior do que seis esse meu vai apresentar
a cor vermelha eu tenho aqui então as duas bactérias vou colocar o vermelho de metila os seus bactérias fermentação a glicose ou produção de ácidos e a gente vai observar a cor amarelo se não houver fermentação da glicose não houve produção de ácidos e a gente vai observar a cor vermelha vamos vamos fazer o teste de produção de indol com esse teste a gente consegue saber se a bactéria consegue utilizar o aminoácido triptofano como fonte de carbono energia as bactérias que possuem a enzima triptofanase degrada um aminoácido triptofano vão produzindo em Doll ácido pirúvico e
amônia Então a gente tem aqui dois cultivos bacterianos crescidos em caldo triptona que é um e encontre tô falando se a bactéria utiliza o triptofano do Meio Window vai se acumular no meio e a gente vai conseguir ver isso adicionando o reativo de como ele reage com o Idol para fazendo um composto Rosado que não é solúvel em água então se a gente observar a formação de um anel Rosado significa que a bactéria produz o indol a partir do triptofano se o anel produzido não tivesse a cor indique no meio não vai dó ou seja
a bactéria não utiliza o tryptophan on e seria praticamente impossível esgotar todos os testes bioquímicos para identificação de bactérias nos vimos três exemplos de uma enorme variedade de festas que podem ser feitos é só pegar uma chave de identificação no livro ver quais os testes bioquímicos necessários para identificar aquele tipo de bactérias e seguindo os protocolos da realização dos Testes não tem erro é consegui uma receita de bolo certo hoje nós ficamos por aqui e aguardo vocês na nossa próxima vídeo aula
Related Videos

12:26
Video Aula 1 - Microbiologia / Equipamento...
bebelazevedo10
4,321 views

56:13
Preparo de meio de cultura
Dra. Carla Leite - Vídeos de Microbiologia
14,059 views
![[BIO] Processo de coloração dos microrganismos](https://img.youtube.com/vi/pygbF23ZryI/mqdefault.jpg)
22:36
[BIO] Processo de coloração dos microrgani...
Nead Unicentro
6,439 views

14:54
Video Aula 8 - Microbiologia / Análise Mic...
bebelazevedo10
5,879 views

59:46
Preparação de meios de cultura em placas d...
PROF. MAYER
27,836 views

29:26
Aula Pratica 5 - Técnicas de isolamento de...
Caio Rachid
4,863 views

6:24
Video Aula 5 - Microbiologia / Preparo de ...
bebelazevedo10
1,634 views

19:17
MORFOLOGIA E ESTRUTURAS DA CÉLULA BACTERIA...
Alexandre Funck
63,600 views

40:32
Microbiologia Médica: Principais Meios de ...
CS Ciências da Saúde
28,087 views

32:20
Microbiologia Médica: Identificação Cocos ...
CS Ciências da Saúde
41,950 views

15:09
ANÁLISE MICROBIOLÓGICA DA ÁGUA (NMP) - PRO...
Alexandre Funck
31,409 views

35:04
Especialização em Ensino de Biologia - Aul...
CIAR UFG
33,430 views

49:57
Microbiologia Médica: Mycobacterium tuberc...
CS Ciências da Saúde
20,213 views

5:51
Sexual Harassment Charlie - SNL
Saturday Night Live
735,872 views

8:00
Coloração de Gram: Bactérias Gram-positiva...
Bio Aulas - Prof. Matheus Moura
199,007 views

32:08
Microbiologia Médica: Controle do crescime...
CS Ciências da Saúde
20,168 views
1:01:01
Microbiologia clínica Aula 1
Canal do Residente Biomédico
13,400 views

4:03
Weekend Update: UnitedHealthcare CEO Shoot...
Saturday Night Live
1,055,979 views

13:11
Biossegurança em Laboratórios de Microbiol...
PROF. MAYER
11,335 views

7:09
Coloração de Gram - Bactérias Gram-positiv...
Bio Aulas - Prof. Matheus Moura
158,885 views